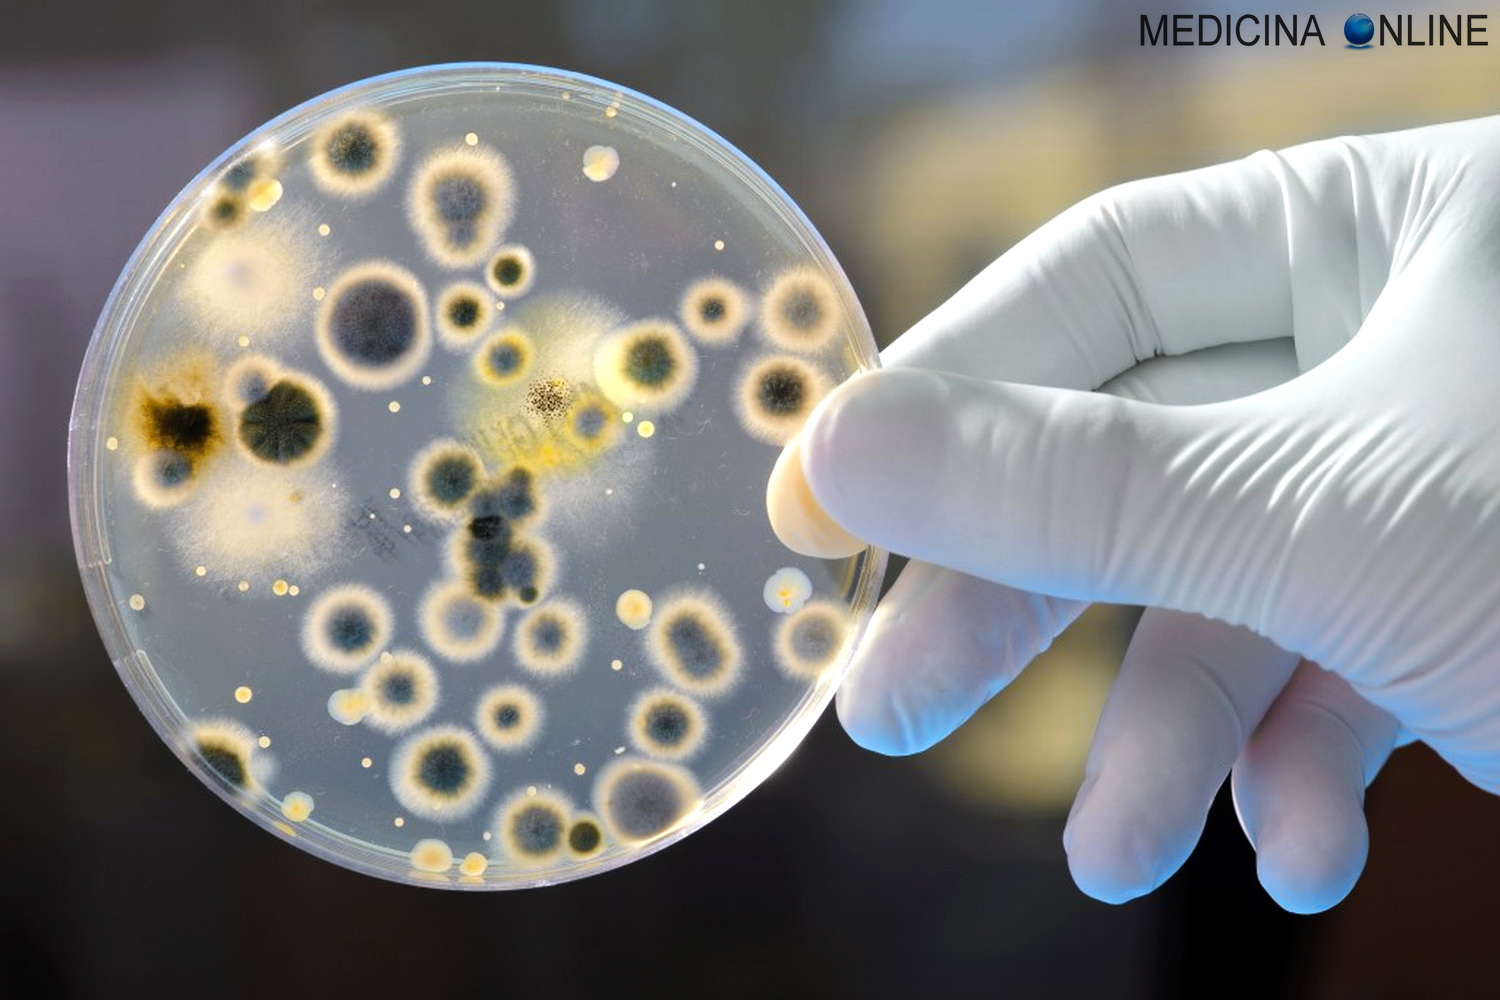

Antibiotico resistenza: dall’Università di Ginevra arrivano nuovi sviluppi per fronteggiare l’emergenza
L’antibiotico-resistenza rappresenta un impatto importante per l’uomo e l’uso indiscriminato di questi farmaci ha selezionato ceppi resistenti agli antibiotici finora utilizzati. Alcuni ricercatori dell’Università di Ginevra hanno identificato il fattore che determina l’infettività di un batterio, Pseudomonas aeruginosa, resistente a molti antibiotici noti. Sono riusciti a neutralizzare il patogeno riducendone il potere infettivo e … Leggi tutto